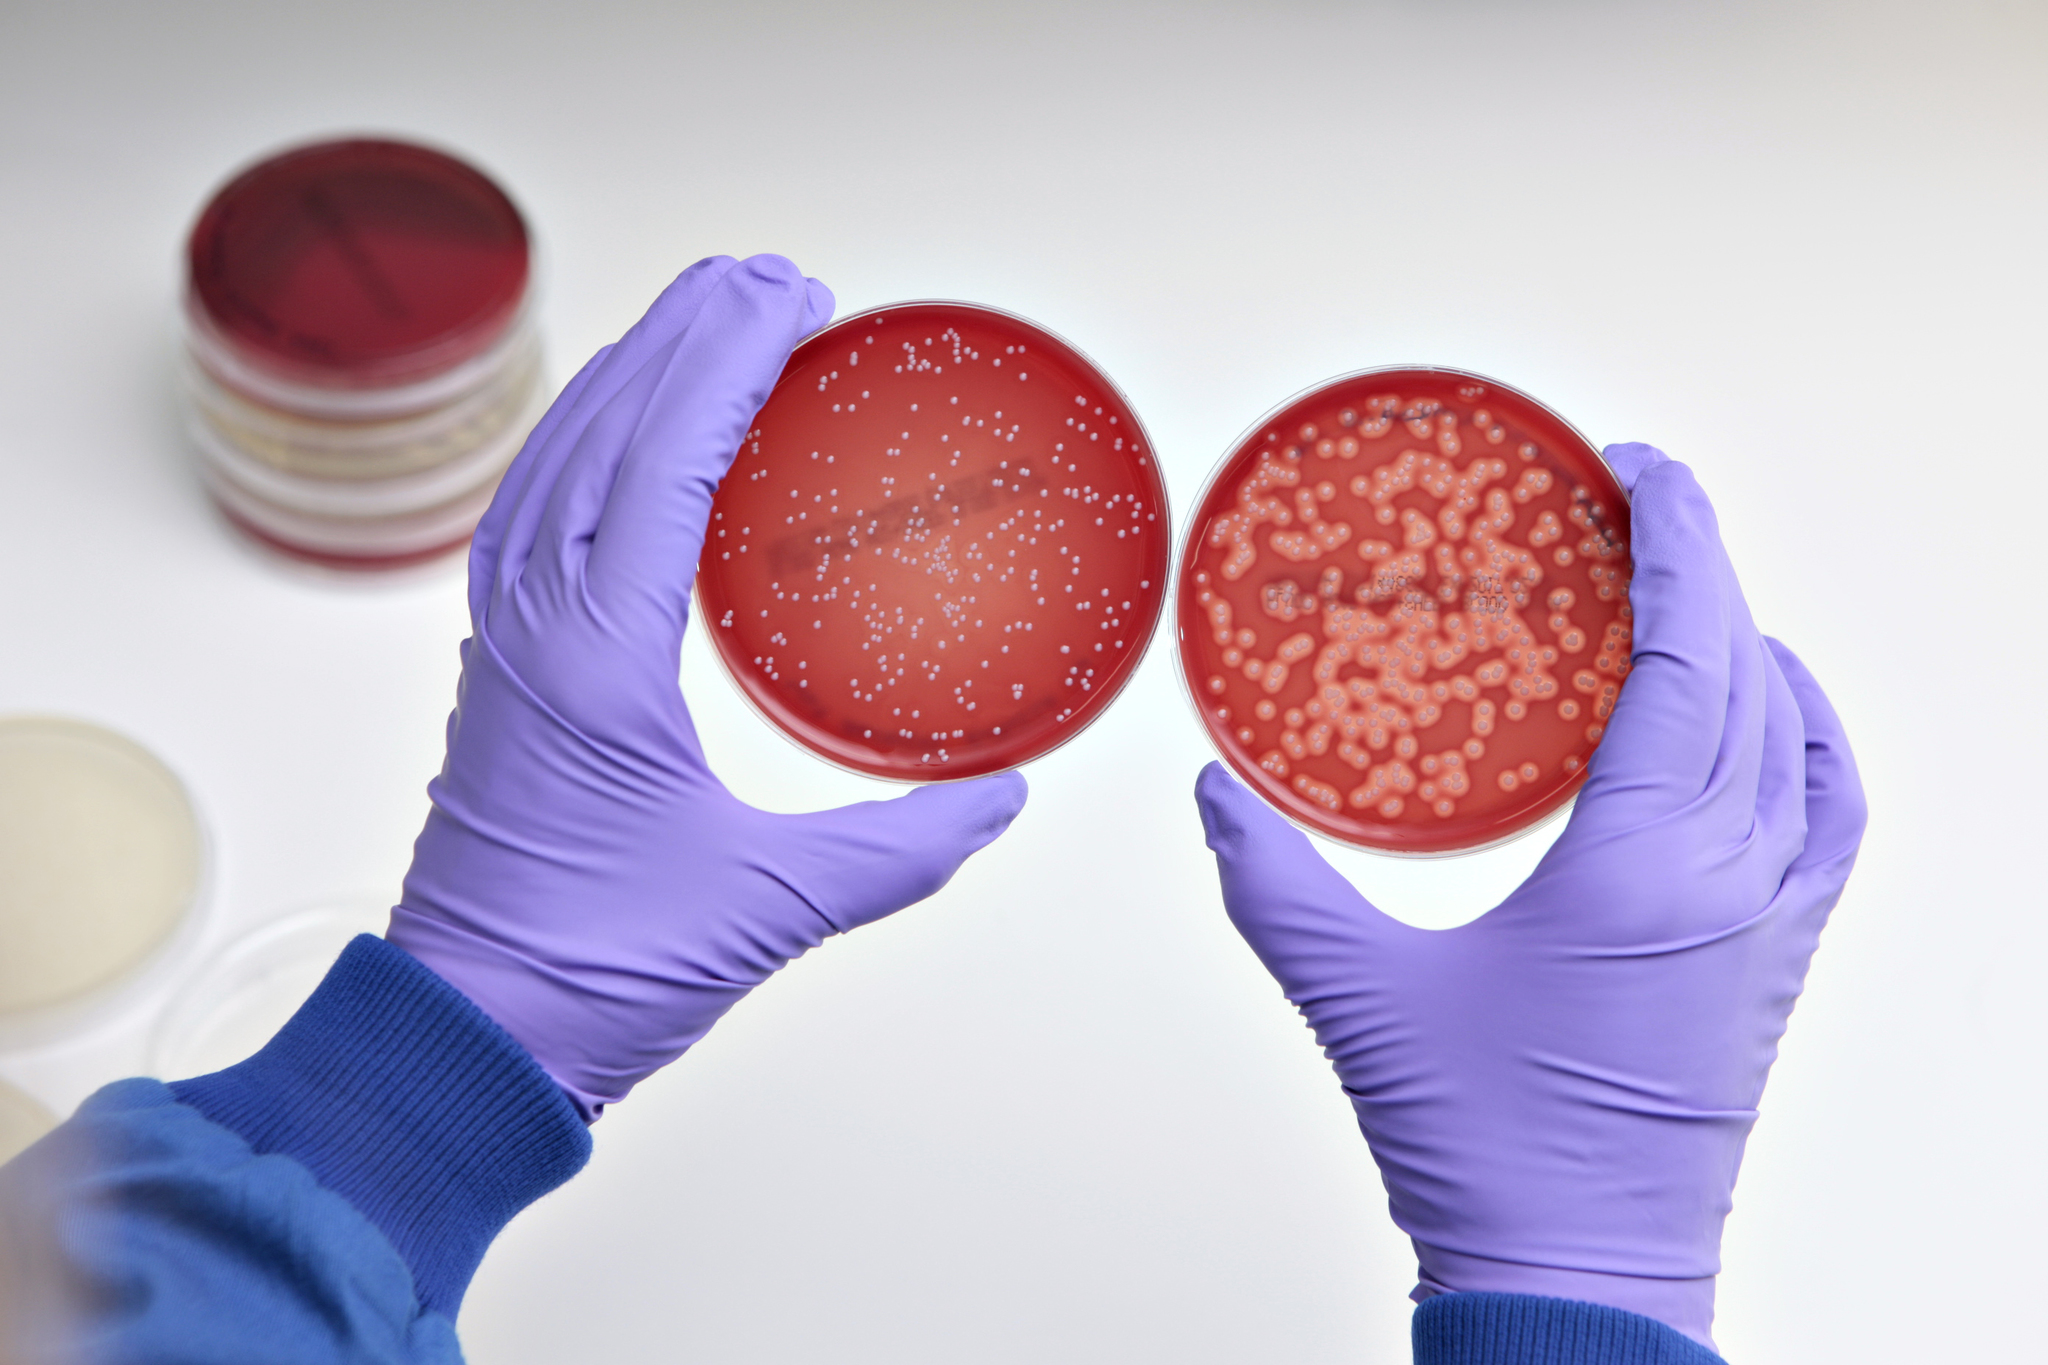

Фото Симптомы Стафилококка

💣 👉🏻👉🏻👉🏻 ИНФОРМАЦИЯ ДОСТУПНА ЗДЕСЬ! КЛИКАЙ 👈🏻👈🏻👈🏻
Фото Зал 18 Кв Метров
Пришли Фото Секса
Купить Рамки Для Фото Дерево
Дошик Из Тик Тока Горячие Фото Слив
Сапоги Куома Детские Зимние Фото
Картинка Дивы Лол
Картинки На Аву Детские
Фото На Аву Аниме Для Пацанов
Купе Сьют Фото
Аппликация Из Ткани Шаблоны Картинки
Фото Голые 11 14
Сексуальный Живой Фото
Готовим С Детьми Простые Рецепты С Фото
Картинки С Днем Учителя Срисовать
Смотреть Картинки Аниме Девушек Интим
Лик Иверской Божьей Матери Фото
Белая Песня Картинки
Здоровые Половые Органы Фото
Черный Турмалин Камень Фото
Дед Детские Картинки
Село Алахадзы Фото
Несъедобные Ягоды Картинки С Названиями
На Какую Сторону Застегивается Мужская Рубашка Фото
Салат Добрая Теща Рецепт С Фото Пошагово
Сжатие Фото Без Потери Качества На Андроид
Sparrow Hills Trail 2022 Фотографии
Как Сделать Правильные Брови Фото
Владимир Жеребцов Жена Дети Фото
Фото Автошколы Реклама
Звезды На Погонах Звания Фото
Школа 34 Рязань Фото
Картофель Кармен Описание Сорта Фото Отзывы
Порно Фото Каком
Жены Андрея Урганта Фото
Фото Красивой Девочки В Очках
Профессия Парикмахер Картинки Для Детей
Большие Груди Голые Фото Актриса
Случайные Откровенные Фото
Коричневые Коты Фото
Любительские Фото Голых Молодых Девушек
Фото На Ночь 18
Осенний Фото Челлендж
Картинки На Хуй Работу
Элина Насырова Ведущая Бст Фото
Пожелания В Новом Дне Картинки Осенние
Кроссоверы Мерседес Модельный Ряд Фото
Системы Счисления Картинки
Олексий Горячие Фото
Фото Частное Секс Геи
Сиськи Зрелых Фото В Джинсах Платье
Стихи Про Осень Короткие В Картинках
Телеведущая Утро России Фото
Парни Отправляют Фото Члена
Тушеное Мясо Говядины Рецепт С Фото
Кухня 3 Метра Прямая С Холодильником Фото
Светлая Прихожая Фото Дизайн В Квартире
Российские Актрисы Брюнетки Фото И Имена
Малыши 5 Лет Фото
Фото Дьяволицы Аниме
Голая В Очках Частные Фото
Фото Шкоды Рапид Серебристой
Парк Белинского Пенза Фото
Масло 5w40 Фото
Бмв Икс 5 Фото
Решить Пример По Фото С Действиями
Сегодня Последний День Картинка
Изменить Фигуру На Фото Онлайн
Картинки 14 Сезона Фортнайт
Фото Дам С Грудями Порно
Как Восстановить Фото На Айфоне После Удаления
Алина Таркинская Фото В Купальнике
Проверка Вина По Фото
Лион Из Игры Бравл Старс Картинка
Живые Старые Фото
С Днем Рождения Гуля Картинки Открытки
Знаки Препинания Фото И Картинки
10 Самых Опасных Фото
Интерьер Совмещенного Туалета Фото
Фото В Бассейне Душе
Виды Духовых Инструментов С Картинками
Сказка Снегурочка Читать С Картинками
Нейлон На Голое Тело Эро Фото
Картинка Добермана Черно Белая
Старые Архивные Фото
Цветы Глициния Посадка И Уход Фото
Американская Вилка Для Розетки Фото
Программы Монтажа Фото Русском
Карта Желаний Сектор Творчество Картинки
Терминатор 2 Актеры И Роли Фото
Нива Гранта Фото
Фото Овсяно Блина
День Работников Торговли Поздравления Прикольные Картинки
Все Модели Ноутбуков Асус Фото
Папа Сын В Зоопарке Фото Подпись
Андрей Литвинов Фото
Анна Цуканова Котт Фото В Детстве
Кицунэ Лис Фото
Фотография Объектива Фотоаппарата
Комнатные Растения С Длинными Листьями Фото
Онлайн Тест Личности По Картинкам
Торт Своими Руками Фото Пошагово
Беседка Своими Руками Фото
Техника Безопасности Глазами Детей Картинки
Фото Симптомы Стафилококка











_SEM.jpg" width="550" alt="Фото Симптомы Стафилококка" title="Фото Симптомы Стафилококка">

_SEM.jpg" width="550" alt="Фото Симптомы Стафилококка" title="Фото Симптомы Стафилококка">












:max_bytes(150000):strip_icc()/staphylococcus_aureus_bac-57bf23e93df78cc16e1dff45.jpg)









